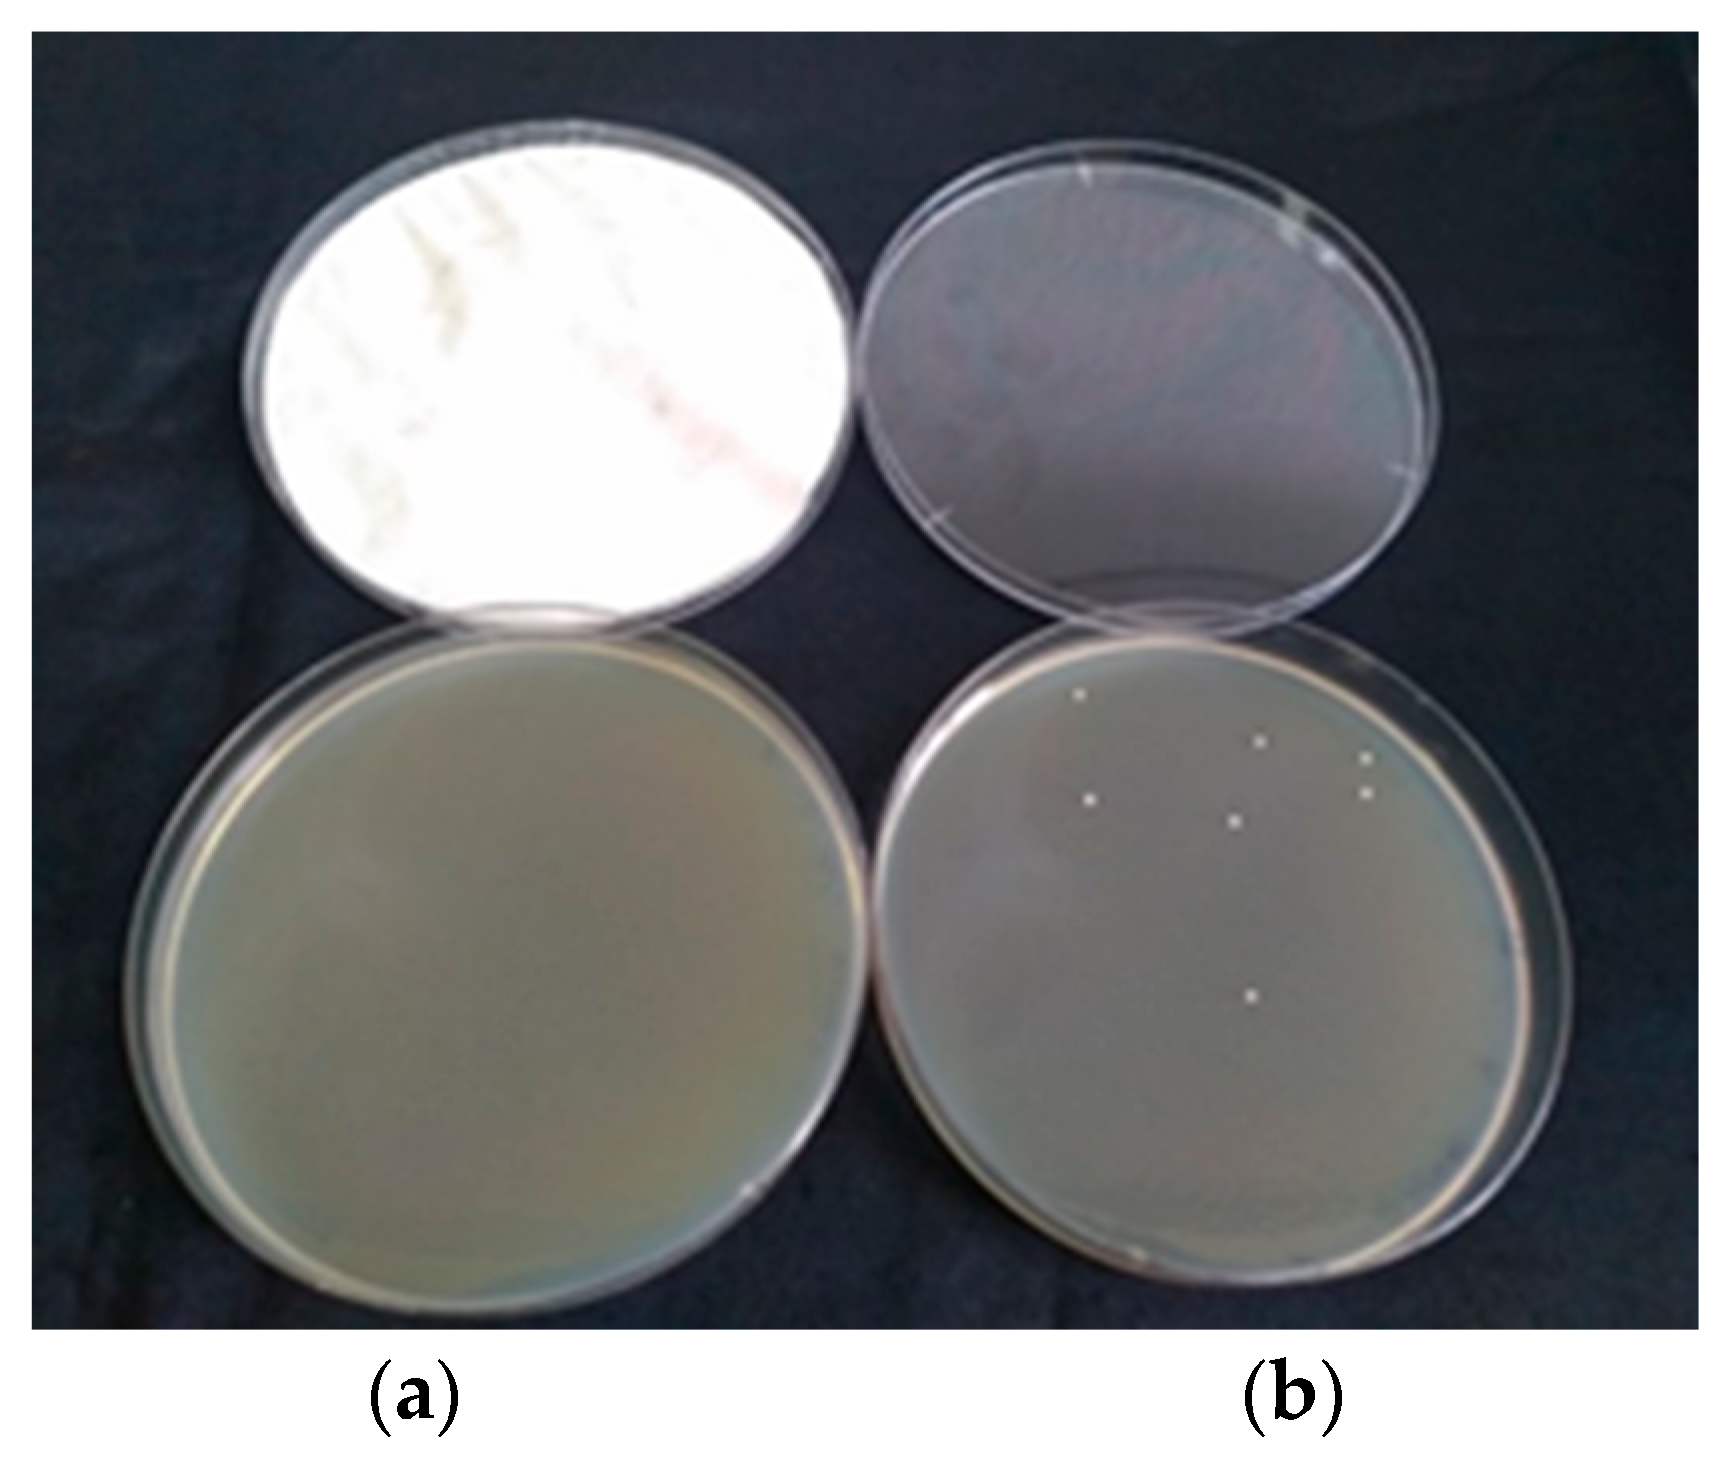
Coatings 09 00470 g011

Antimicrobial Paper Coatings Containing Microencapsulated Cymbopogon citratus Oil
Abstract
:1. Introduction
1.1. Microencapsulation in Paper Industries
1.2. Microencapsulated Antimicrobial Essential Oils
1.3. Research Aim and Objectives
2. Materials and Methods
2.1. Microencapsulation with Complex Coacervation
2.2. Microencapsulation with In Situ Polymerization
2.3. Paper Coating with Microcapsule Suspensions
2.4. Pressure-Activation of Microcapsules—Weight Pulling Test
2.5. Morphology and Visualization of Microcapsules
2.6. Determination of Minimum Inhibitory Concentrations (MIC) of Encapsulated and Non-Encapsulated Citronella Oil in Liquid Media
2.7. Coated Papers Antimicrobial Activity Tests on Agar Plates in Petri Dishes
2.8. Statistical Analysis
3. Results and Discussion
3.1. Citronella Oil Microcapsules Produced with Complex Coacervation
3.2. Citronella Oil Microcapsules Produced with In Situ Polymerization
3.3. Coated Papers
3.4. Mechanical Activation of Microcapsules on Paper
3.5. Antimicrobial Activity
3.5.1. MIC of Non-Encapsulated and Microencapsulated Citronella Oil
3.5.2. Antimicrobial Activity of Coated Papers
4. Conclusions
Author Contributions
Funding
Conflicts of Interest
References
- Arshady, R. Microspheres Microcapsules Liposomes: Preparation Chemical Applications; Citus Reference Series, MML Series; Citus Books: London, UK, 1999; p. 576. [Google Scholar]
- Ghosh, S.K. Functional Coatings: By Polymer Microencapsulation; Wiley-VCH: Weinheim, Germany, 2006; p. 357. [Google Scholar]
- Benita, S. Microencapsulation: Methods and Industrial Applications, 2nd ed.; Taylor & Francis: New York, NY, USA, 2006; p. 781. [Google Scholar]
- Miller, R.E.; Brown, R.W. Pressure-Sensitive Record Material. U.S. Patent US4675706A, 23 June 1987. [Google Scholar]
- Kukovič, M. Tiskarska Brezsajna Kopirna Barva. Slovenia Patent SI9300539A, 30 April 1995. [Google Scholar]
- Junji, H.; Takaaki, K.; Sukeharu, W. Self-Color Forming Pressure- and Heat-Sensitive Recording Sheet. Japan Patent JP10264516A, 4 April 1998. [Google Scholar]
- Satoshi, N. Pressure Sensitive Fluorescent Complex. Japan Patent JP11198527A, 27 July 1999. [Google Scholar]
- Hirasawa, A.; Naoi, S. Back Carbon Ink, and Tamperproof Pressure-Sensitive Copying Sheet Using the Same. Japan Patent JP2002129077A, 9 May 2002. [Google Scholar]
- Kukovič, M.; Knez, E. Postopek Priprave Nosilcev, Impregniranih ali Premazanih z Mikrokapsuliranimi Dišavami. Slovenia Patent SI9400362A, 30 April 1996. [Google Scholar]
- Watanabe, M.; Watanabe, Y.; Kawasaki, K.; Ogawa, A.; Yoshimatsu, T.; Kato, S.; Otohata, T. Printing Paper Containing Microcapsules of Oily Substances. Japan Patent JP2014169512A, 18 Spetember 2014. [Google Scholar]
- Fan, Y.; Fengchun, J.; Xiaobo, X.; Na, W.; Huqi, T. Cigarette Paper. China Patent CN103362033A, 23 October 2013. [Google Scholar]
- Eom, J.K. Printing Paper Capable of Emitting Natural Aroma. Korea Patent KR791060B, 3 January 2008. [Google Scholar]
- Hirata, N. Method of Producing Scented Tissue Paper Product. U.S. Patent US20170175336A1, 22 June 2017. [Google Scholar]
- Dong, C.; Liu, Y.; Long, Z.; Pang, Z.; Yunhui, L.; Li, X. Effect of papermaking conditions on the retention of reversible thermochromic microcapsule in paper. BioResources 2011, 7, 66–77. [Google Scholar]
- Li, X.; Zhang, N.; Sun, S.; Lai, W.; Fu, G. Imaging Method and Printer Applaying Photo-Thermal Sensitive Material. China Patent CN101020394A, 22 August 2007. [Google Scholar]
- Lewis, M.W.; Rosenbaum, J.C.; Herbert, A.J.; Attri, P. Microsencapsulated System for Thermal Paper. U.S. Patent US5741592A, 21 April 1998. [Google Scholar]
- Li, J.; Zou, J.; Xiao, H.; He, B.; Hou, X.; Qian, L. Preparation of novel nano-sized hydrogel microcapsules via layer-by-layer assembly as delivery vehicles for drugs onto hygiene paper. Polymers 2018, 10, 335. [Google Scholar] [CrossRef] [PubMed]
- Romano, V. Disposable Paper Sheet Comprising a Antimicrobial and Antibacterial Substance and Its Method of Manufacture. European Patent EP2583593A1, 24 April 2013. [Google Scholar]
- Nanbu, Y.; Ujii, M. Foamed Wallpaper. Japan Patent JP2018066089A, 26 April 2018. [Google Scholar]
- Jayet Laraffe, C.; Rosset, H. Information Carrier Having Biocidal Properties and Method of Manufacturing the Same. France Patent FR2838025A1, 10 October 2003. [Google Scholar]
- Hamu, S.; Takeuchi, T. Antibacterial Regenerated Artificial Leather Paper. Japan Patent JPH11172581A, 29 June 1999. [Google Scholar]
- Watanabe, N. Wiping Papers and Their Manufacture. Japan Patent JP06125862A, 10 May 1994. [Google Scholar]
- Fan, Y. Antimicrobial Waterproofing Paper, and Preparation Method Thereof. China Patent CN107780306A, 9 March 2018. [Google Scholar]
- Li, Y.; Lei, Y.; Wei, L. Preparation Method of Color-Developing Antimicrobial Sucrose Wrapping Paper. China Patent CN107604752A, 19 January 2018. [Google Scholar]
- Singh, S.; Gaikwad, K.K.; Lee, M.; Lee, Y.S. Microwave-assisted micro-encapsulation of phase change material using zein for smart food packaging applications. J. Therm. Anal. Calorim. 2018, 131, 2187–2195. [Google Scholar] [CrossRef]
- Li, L. Preparation Method of Environment-Friendly Antibacterial Antioxidative Packaging Paper. China Patent CN108716166A, 30 October 2018. [Google Scholar]
- Merino Ciudad, J. Smart Container for Food and Fluids. Patent WO2016128594A, 18 August 2016. [Google Scholar]
- Ko, G.S. Manufacturing Method of Raw Material Paper of Packaging Box for Agricultural Products for Extending Storage Expiration Date. Korea Patent KR1771353B, 24 August 2017. [Google Scholar]
- Wang, S.; Zhang, X. Medical Heat-Sensitive Paper. China Patent CN104228385A, 24 December 2014. [Google Scholar]
- Noda Plywood Mfg. Co. Fabrication of Hydraulic Building Boards. Japan Patent JP60028776B, 6 July 1985.
- Lin, Y. An Efficient Waste Paper Deinking Agent. China Patent CN105086584A, 25 November 2015. [Google Scholar]
- Wang, S.; Zhang, X. Method for Manufacturing Microcapsule with Improved Dye-Releasing Controllability for Image Coating Electronic Ink Used in Electronic Paper. Korea Patent KR2017112154A, 12 October 2017. [Google Scholar]
- Sheng, M.; Zhang, L.; Guan, Y.; Li, L.; Fu, S. The photoelectric properties characteristics of dye-doped nematic liquid crystal microcapsules with different structural composition. J. Mol. Liq. 2019, 283, 816–822. [Google Scholar] [CrossRef]
- Kim, C.A.; Oh, J. Color Electronic Paper Displays Using Black Matrices and Methods of Fabricating the Same. U.S. Patent US20130163067A1, 27 June 2013. [Google Scholar]
- Rodriguez, A.; Batlle, R.; Nerin, C. The use of natural essential oils as antimicrobial solutions in paper packaging. Part II. Prog. Org. Coat. 2017, 60, 33–38. [Google Scholar] [CrossRef]
- Manso, S.; Cacho-Nerin, F.; Becerril, R.; Nerín, C. Combined analytical and microbiological tools to study the effect on Aspergillus flavus of cinnamon essential oil contained in food packaging. Food Control 2013, 30, 370–378. [Google Scholar] [CrossRef]
- Atarés, L.; Chiralt, A. Essential oils as additives in biodegradable films and coatings for active food packaging. Trends Food Sci. Technol. 2016, 48, 51–62. [Google Scholar] [CrossRef]
- Bustos, R.O.; Alberti, F.V.; Matiacevich, S.B. Edible antimicrobial films based on microencapsulated lemongrass oil. J. Food Sci. Technol. 2016, 53, 832–839. [Google Scholar] [CrossRef]
- Ribeiro-Santos, R.; Andrade, M.; Sanches-Silva, A. Application of encapsulated essential oils as antimicrobial agents in food packaging. Curr. Opin. Food Sci. 2017, 14, 78–84. [Google Scholar] [CrossRef]
- Ribeiro-Santos, R.; Andrade, M.; de Melo, N.R.; Sanches-Silva, A. Use of essential oils in active food packaging: Recent advances and future trends. Trends Food Sci. Technol. 2017, 61, 132–140. [Google Scholar] [CrossRef]
- Alarcón-Moyano, J.K.; Bustos, R.O.; Herrera, M.L.; Matiacevich, S.B. Alginate edible films containing microencapsulated lemongrass oil or citral: Effect of encapsulating agent and storage time on physical and antimicrobial properties. J. Food Sci. Technol. 2017, 54, 2878–2889. [Google Scholar] [CrossRef] [PubMed]
- Sacchetti, G.; Maietti, S.; Muzzoli, M.; Scaglianti, M.; Manfredini, S.; Radice, M.; Bruni, R. Comparative evaluation of 11 essential oils of different origin as functional antioxidants, antiradicals and antimicrobials in foods. Food Chem. 2005, 91, 621–632. [Google Scholar] [CrossRef]
- Matasyoh, J.C.; Wagara, I.N.; Nakavuma, J.L. Chemical composition of Cymbopogon citratus essential oil and its effect on mycotoxigenic Aspergillus species. Afr. J. Food Sci. 2011, 5, 138–142. [Google Scholar]
- Bassolé, I.H.N.; Lamien-Meda, A.; Bayala, B.O.L.C.; Obame, L.C.; Ilboudo, A.J.; Franz, C.; Dicko, M.H. Chemical composition and antimicrobial activity of Cymbopogon citratus and Cymbopogon giganteus essential oils alone and in combination. Phytomedicine 2011, 18, 1070–1074. [Google Scholar] [CrossRef] [PubMed]
- Fadli, M.; Pagès, J.M.; Mezrioui, N.E.; Abbad, A.; Hassani, L. Artemisia herba-alba Asso and Cymbopogon citratus (DC.) Stapf essential oils and their capability to restore antibiotics efficacy. Ind. Crop. Prod. 2016, 89, 399–404. [Google Scholar] [CrossRef]
- Essential Oils Direct. Lemongrass Oil—Material Safety Data Sheet. Available online: https://www.essentialoilsdirect.co.uk/aromatherapy/msds/lemongrass_oil_essential_oil.pdf (accessed on 29 March 2018).
- Xiao, Z.; Liu, W.; Zhu, G.; Zhou, R.; Niu, Y. A review of the preparation and application of flavour and essential oils microcapsules based on complex coacervation technology. J. Sci. Food Agric. 2014, 94, 1482–1494. [Google Scholar] [CrossRef]
- Majeed, H.; Bian, Y.Y.; Ali, B.; Jamil, A.; Majeed, U.; Khan, Q.F.; Fang, Z. Essential oil encapsulations: Uses, procedures, and trends. RSC Adv. 2015, 5, 58449–58463. [Google Scholar] [CrossRef]
- El Asbahani, A.; Miladi, K.; Badri, W.; Sala, M.; Addi, E.A.; Casabianca, H.; Elaissari, A. Essential oils: From extraction to encapsulation. Int. J. Pharm. 2015, 483, 220–243. [Google Scholar] [CrossRef]
- Bakry, A.M.; Abbas, S.; Ali, B.; Majeed, H.; Abouelwafa, M.Y.; Mousa, A.; Liang, L. Microencapsulation of oils: A comprehensive review of benefits, techniques, and applications. Compr. Rev. Food Sci. Food Saf. 2016, 15, 143–182. [Google Scholar] [CrossRef]
- Rodríguez, J.; Martín, M.J.; Ruiz, M.A.; Clares, B. Current encapsulation strategies for bioactive oils: From alimentary to pharmaceutical perspectives. Food Res. Int. 2016, 83, 41–59. [Google Scholar] [CrossRef]
- Urbas, R.; Milošević, R.; Kašiković, N.; Pavlović, Ž.; Elesini, U.S. Microcapsules application in graphic arts industry: A review on the state-of-the-art. Iran. Polym. J. 2017, 26, 541–561. [Google Scholar] [CrossRef]
- Hsieh, W.C.; Chang, C.P.; Gao, Y.L. Controlled release properties of chitosan encapsulated volatile citronella oil microcapsules by thermal treatments. Colloids Surf. B Biointerfaces 2006, 53, 209–214. [Google Scholar] [CrossRef] [PubMed]
- Leimann, F.V.; Gonçalves, O.H.; Machado, R.A.; Bolzan, A. Antimicrobial activity of microencapsulated lemongrass essential oil and the effect of experimental parameters on microcapsules size and morphology. Mater. Sci. Eng. C 2009, 29, 430–436. [Google Scholar] [CrossRef]
- Miro Specos, M.M.; Garcia, J.J.; Tornesello, J.; Marino, P.; Vecchia, M.D.; Tesoriero, M.D.; Hermida, L.G. Microencapsulated citronella oil for mosquito repellent finishing of cotton textiles. Trans. R. Soc. Trop. Med. Hyg. 2010, 104, 653–658. [Google Scholar] [CrossRef]
- Solomon, B.; Sahle, F.F.; Gebre-Mariam, T.; Asres, K.; Neubert, R.H.H. Microencapsulation of citronella oil for mosquito-repellent application: Formulation and in vitro permeation studies. Eur. J. Pharm. Biopharm. 2012, 80, 61–66. [Google Scholar] [CrossRef]
- Liu, C.H.; Zhou, H.J.; Liu, J.Y.; Li, X.T.; Fang, H.; Yang, Z.H. Preparation of antibacterial citronella oil microcapsules and their application in cotton fabrics. Adv. Mater. Res. 2013, 627, 271–274. [Google Scholar] [CrossRef]
- Aziz, F.R.A.; Jai, J.; Raslan, R.; Subuki, I. Microencapsulation of citronella oil by complex coacervation using chitosan-gelatine system: Operating design, preparation and characterization. MATEC Web Conf. 2016, 69, 04002. [Google Scholar] [CrossRef]
- Bezerra, F.M.; Carmona, O.G.; Carmona, C.G.; Lis, M.J.; de Moraes, F.F. Controlled release of microencapsulated citronella essential oil on cotton and polyester matrices. Cellulose 2016, 23, 1459–1470. [Google Scholar] [CrossRef]
- Ribeiro, A.D.; Marques, J.; Forte, M.; Correia, F.C.; Parpot, P.; Oliveira, C.; Alves, G.M. Microencapsulation of citronella oil for solar-activated controlled release as an insect repellent. Appl. Mater. Today 2016, 5, 90–97. [Google Scholar] [CrossRef] [Green Version]
- Khounvilay, K.; Estevinho, B.N.; Rocha, F.A.; Oliveira, J.M.; Vicente, A.; Sittikijyothin, W. Microencapsulation of citronella oil with carboxymethylated tamarind gum. Walailak J. Sci. Technol. (WJST) 2017, 15, 515–527. [Google Scholar]
- De Matos, E.F.; Scopel, B.S.; Dettmer, A. Citronella essential oil microencapsulation by complex coacervation with leather waste gelatine and sodium alginate. J. Environ. Chem. Eng. 2018, 6, 1989–1994. [Google Scholar] [CrossRef]
- Songkro, S.; Yapong, P.; Puechpan, P.; Maneenuan, D.; Boonme, P. Microencapsulation of citronella oil for mosquito repellent: Preparation and evaluation of release characteristics. Songklanakarin J. Sci. Technol. 2018, 40, 767–775. [Google Scholar]
- De Freitas Souza, C.; Rampelotto, C.; Loureiro, B.B.; Pereira, F.A.; Bianchini, A.E.; Corcini, C.D.; Bertolin, K. Effects of dietary microencapsulated Cymbopogon flexuosus essential oil on reproductive-related parameters in male Rhamdia quelen. Fish Physiol. Biochem. 2018, 44, 1253–1264. [Google Scholar] [CrossRef] [PubMed]
- Bhatt, L.; Singh, S.S.J. Comparative analysis of lemongrass oil application on textile substrate through microencapsulation and exhaust method. Int. J. Adv. Res. Sci. Eng. 2018, 7, 313–320. [Google Scholar]
- Wang, J.; Li, X.; Chen, M.; Chen, Z.; Wu, H.; Zhang, P.; Hu, Y. Fabrication of sustained-release and antibacterial citronella oil-loaded composite microcapsules based on Pickering emulsion templates. J. Appl. Polym. Sci. 2018, 135, 46386. [Google Scholar] [CrossRef]
- Vázquez-Sánchez, D.; Cabo, M.L.; Rodríguez-Herrera, J.J. Antimicrobial activity of essential oils against Staphylococcus aureus biofilms. Food Sci. Technol. Int. 2015, 21, 559–570. [Google Scholar] [CrossRef] [PubMed]
- Saddiq, A.A.; Khayyat, S.A. Chemical and antimicrobial studies of monoterpene: Citral. Pestic. Biochem. Physiol. 2010, 98, 89–93. [Google Scholar] [CrossRef]
- Ohno, T.; Kita, M.; Yamaoka, Y.; Imamura, S.; Yamamoto, T.; Mitsufuji, S.; Imanishi, J. Antimicrobial activity of essential oils against Helicobacter pylori. Helicobacter 2003, 8, 207–215. [Google Scholar] [CrossRef]
- Naik, M.I.; Fomda, B.A.; Jaykumar, E.; Bhat, J.A. Antibacterial activity of lemongrass (Cymbopogon citratus) oil against some selected pathogenic bacterias. Asian Pac. J. Trop. Med. 2010, 3, 535–538. [Google Scholar] [CrossRef]
- Boh, B.; Knez, E.; Starešinič, M. Microencapsulation of higher hydrocarbon phase change materials by in situ polymerization. J. Microencapsul. 2005, 22, 715–735. [Google Scholar] [CrossRef]
- Xing, F.; Cheng, G.; Yi, K.; Ma, L. Nanoencapsulation of capsaicin by complex coacervation of gelatine, acacia, and tannins. J. Appl. Polym. Sci. 2005, 96, 2225–2229. [Google Scholar] [CrossRef]
- Sun, G.; Zhang, Z. Mechanical strength of microcapsules made of different wall materials. Int. J. Pharm. 2002, 242, 307–311. [Google Scholar] [CrossRef]
- Hu, J.; Chen, H.-Q.; Zhang, Z. Mechanical properties of melamine-formaldehyde microcapsules for self-healing materials. Mater. Chem. Phys. 2009, 118, 63–70. [Google Scholar] [CrossRef]
- Pan, X.; York, D.; Preece, J.-A.; Zhang, Z. Size and strength distributions of melamine-formaldehyde microcapsules prepared by membrane emulsification. Powder Technol. 2012, 227, 43–50. [Google Scholar] [CrossRef]
- Chung, S.K.; Seo, J.Y.; Lim, J.H.; Park, H.H.; Yea, M.J.; Park, H.J. Microencapsulation of essential oil for insect repellent in food packaging system. J. Food Sci. 2013, 78, E709–E714. [Google Scholar] [CrossRef]
- Zhao, H.; Fei, X.; Cao, L.; Zhang, B.; Liu, X. The fabrication of fragrance microcapsules and their sustained and broken release behaviour. Materials 2019, 12, 393. [Google Scholar] [CrossRef] [PubMed]
- Donsi, F.; Annunziata, M.; Sessa, M.; Ferrari, G. Nanoencapsulation of essential oils to enhance their antimicrobial activity in foods. LWT-Food Sci. Technol. 2011, 44, 1908–1914. [Google Scholar] [CrossRef]

| Application/Topic | Examples | References |
|---|---|---|
| Pressure-sensitive copying paper | multi-layered business forms, security papers, labels, single-layer pressure and heat-sensitive recording paper, self-contained printing inks, forgery-resistant back carbon ink | [4,5,6,7,8] |
| Fragranced papers | fragranced printing paper, promotional materials, sticky notes, scented tissue paper, aromatherapy, cigarette paper, gift box paper | [9,10,11,12,13] |
| Thermochromic and photosensitive papers | thermochromic papers, UV fixable thermal films, two colour thermal papers, thermally fixing photosensitive papers | [14,15,16] |
| Antimicrobial paper products | hygiene papers, wallpapers, wrapping papers, disposable paper sheets, disposable wiping papers, antibacterial regenerated artificial leather paper, antimicrobial waterproofing paper, data carrier products | [17,18,19,20,21,22,23,24] |
| Smart packaging | functional paper packaging for agricultural products, antibacterial and antioxidative packaging papers, smart food packaging containing phase change materials, medical heat-sensitive papers, smart container for food and fluids with temperature detection | [25,26,27,28,29] |
| Insulation papers | paper formulations for gypsum building boards | [30] |
| Recyclable papers | deinking of waste paper with microencapsulated enzymes | [31] |
| Electronic papers | electronic papers based on microencapsulated liquid crystals or microencapsulated pigments | [32,33,34] |
| Authors | Method and Wall Materials | Microcapsule Sizes | Applications |
|---|---|---|---|
| Hsieh et al. [53] | modified orifice method, chitosan walls | 20–225 μm | no data |
| Leimann et al. [54] | simple coacervation of poly(vinyl alcohol) | 10–250 μm | antimicrobial |
| Miro Specos et al. [55] | complex coacervation of gelatine and gum arabic | 25–100 μm | mosquito repellent finishing of cotton textiles |
| Solomon et al. [56] | simple coacervation of gelatine by sodium sulphate | no data | mosquito repellent topical formulations—ointments |
| Liu et al. [57] | complex coacervation of gelatine and gum arabic | 10 μm | antimicrobial cotton fabrics |
| Aziz et al. [58] | complex coacervation of gelatine and chitosan, with proanthocyanidins as crosslinkers | 82–157 μm | no data |
| Bezerra et al. [59] | complex coacervation of gelatine and gum arabic | 1–18 μm | textiles: cotton and polyester fabrics |
| Ribeiro et al. [60] | interfacial polymerization of isocyanate and 1,4-butene-diol; polyurethane wall functionalisation with TiO2 nanoparticles | 50–250 μm | solar-activated controlled release mosquito repellents |
| Bustos et al. [38] | emulsification-separation method, sodium caseinate wall | average 22 μm | edible antimicrobial films for food products |
| Khounvilay et al. [61] | spray drying, carboxymethylated tamarind gum walls | 3.8–6.3 μm | not specified |
| Alarcón-Moyano et al. [41] | Trehalose Capsul© | emulsion droplets 1.6–2.3 μm | edible antimicrobial films for fresh foods |
| de Matos et al. [62] | complex coacervation of leather waste gelatine and sodium alginate; leather waste gelatine and sodium alginate | average 434 μm | mosquito nets suggested |
| Songkro et al. [63] | complex coacervation of gelatine and gum arabic | different sizes, optimal 8 μm | mosquito repellents |
| de Freitas Souza [64] | complex coacervation | no data | diets for fish, to improve protein deposition and fish yield |
| Bhatt & Singh [65] | complex coacervation of gelatine and gum arabic | no data | textiles: fragranced antimicrobial cotton fabric |
| Wang et al. [66] | combination of oil-in-water (o/w) Pickering emulsion templates, electrostatic adsorption and chelation methods; composite walls of hydroxyapatite nanoparticles/quaternary ammonium salt of chitosan/sodium alginate | average 13.6 μm | antimicrobial |
| Reference | Antimicrobial Assay | Results |
|---|---|---|
| Leimann et al. [54] | Microdilution method in liquid media, with dimethyl sulfoxide (DMSO) | MIC of pure citronella oil: Escherichia coli 22.32 mg/mL, Staphylococcus aureus 22.32 mg/mL; MIC of citronella oil extracted from microcapsules: Escherichia coli 2.79 mg/mL, Staphylococcus aureus 2.79 mg/mL |
| Liu et al. [57] | shake flask method GB 15979-2002 and agar plates | confirmed antibacterial properties of fabrics with microencapsulated citronella oil (no quantitative data) |
| Bustos et al. [38] | Multiscan Go device with well plates, liquid cultures | inhibited growth of Escherichia coli and Listeria monocytogenes at 1250 ppm citronella oil concentration in the film; equivalent to 5 ppm citronella oil concentration in the medium after 10 h of incubation |
| Alarcón-Moyano et al. [41] | 1 cm2 pieces of film placed on agar plates inoculated with E. coli | MIC of alginate-citronella oil suspension film: Escherichia coli 0.3% v/v; MIC of the film without citronella oil: 0.6% v/v |
| Bhatt & Singh [65] | AATCC 100 method—Assessment of Antibacterial Finishes on Textile Materials | 80% reduction in bacterial colonies in citronella oil microcapsule treated fabric, compared to non-treated fabric |
| Wang et al. [66] | Disc-diffusion (agar plates) and MIC method | MIC of microcapsules: Escherichia coli 0.625 mg/mL, Staphylococcus aureus 0.625 mg/mL; MIC of walls—empty microcapsules: Escherichia coli 2.25 mg/mL, Staphylococcus aureus 2.25 mg/mL |
| Parameters | Batch Codes | ||||
|---|---|---|---|---|---|
| G-CMC-1 | G-GA-6 | G-GA-7 | G-GA-8 | G-GA-9 | |
| Water (g) | 80 | 125.0 | 125.0 | 125.0 | 125.0 |
| Gelatine (g) | 10 | 2.5 | 2.5 | 2.5 | 2.5 |
| Sodium dodecyl sulphate (g) | 0.0 | 0.0 | 0.1 | 0.0 | 0.1 |
| Citronella oil (g) | 40.0 | 30.0 | 30.0 | 30.0 | 30.0 |
| Emulsification | 800 rpm, 10 min | 600 rpm, 30 min | 600 rpm, 30 min | 600 rpm, 30 min | 600 rpm, 30 min |
| Carboxymethyl cellulose 2% aq. solution (g) | 160.0 | 0.0 | 0.0 | 0.0 | 0.0 |
| Gum arabic (g) | 0.0 | 2.5 | 2.5 | 2.5 | 2.5 |
| Water (g) | 170.0 | 125.0 | 125.0 | 125.0 | 125.0 |
| 10% acetic acid (g) | 2.5 | 2.0 | 2.0 | 2.0 | 2.0 |
| Coacervation | pH 4.3, 800 rpm, 2 h | pH = 3.9, 600 rpm, 1 h | pH = 3.9, 600 rpm, 1 h | pH = 3.9, 600 rpm, 1 h | pH = 3.9, 600 rpm, 1 h |
| 25% glutaraldehyde (g) | 3.0 | 5.0 | 5.0 | 0.0 | 0.0 |
| 10% tannin (g) | 0 | 0.0 | 0.0 | 10.0 | 10.0 |
| Core in final suspension (%) | 8.59 | 10.3 | 10.3 | 10.1 | 10.1 |
| Wall in final suspension (%) | 2.84 | 1.71 | 1.71 | 1.68 | 1.68 |
| Microcapsule core/wall ratio | 3.0 | 6.0 | 6.0 | 6.0 | 6.0 |
| Parameter | Value |
| Filling | 400–1200 mL |
| Concentration of modifying agent | 4%–6.5% |
| Concentration of core material | 25%–40% |
| Concentration of wall material | 20–50 g/100 g core material |
| Emulsification | 1600 rpm, 30 min, room T |
| Wall formation–polymerization | 1600 rpm, 60 min, 70–80 °C |
| Diameter of microcapsules | 1–15 µm |
| Microcapsule content in final suspension | 30%–45% |
| Parameter | Value |
|---|---|
| Appearance | white suspension |
| Microcapsule content | 43% |
| Wall material | Melamine-formaldehyde resin |
| Core material | Pure citronella oil |
| Microcapsule size | 1–15 μm |
| pH | 6–7.5 |
| Viscosity | 200–400 MPa s |
| Microencapsulation efficiency | more than 95% |
| Microorganism | Non-Encapsulated Citronella Oil | Coacervation Microcapsules with Citronella Oil | Coacervation Microcapsules without Core | in situ Microcapsules with Citronella Oil | in situ Microcapsules without Core |
|---|---|---|---|---|---|
| E. coli | 0.2% < MIC > 0.04% | 0.07% < MIC > 0.014% | no inhibition | MIC > 1.72% | no inhibition |
| P. aeruginosa | MIC > 0.11% | 0.07% < MIC > 0.014% | MIC > 1.72% | MIC > 1.72% | no inhibition |
| B. subtilis | 0.2% < MIC > 0.04% | 0.07% < MIC > 0.014% | MIC > 1.72% | 1.72% < MIC > 0.34% | MIC > 1.72% |
| S. cerevisiae | MIC > 0.2% | 1.72% < MIC > 0.34% | no inhibition | MIC > 1.72% | no inhibition |
| Time | Blank Samples (CFU/plate) | Samples with Activated Paper (CFU/plate) | ||||||
|---|---|---|---|---|---|---|---|---|
| E. coli 102 | E. coli 101 | S. cerevisiae 102 | S. cerevisiae 101 | E. coli 102 | E. coli 101 | S. cerevisiae 102 | S. cerevisiae 101 | |
| 24 h | 58 ± 7.3 | 2.7 ± 0.9 | 46 ± 6.5 | 8.3 ± 2.1 | 0 | 0 | 0 | 0 |
| 48 h | 87 ± 45 | 2.7 ± 0.9 | 61.7 ± 5.9 | 8.3 ± 2.1 | 5.3 ± 3.1 | 0.3 ± 0.5 | 41.3 ± 10.3 | 2.7 ± 1.7 |
© 2019 by the authors. Licensee MDPI, Basel, Switzerland. This article is an open access article distributed under the terms and conditions of the Creative Commons Attribution (CC BY) license (http://creativecommons.org/licenses/by/4.0/).
Share and Cite
Šumiga, B.; Šumiga, B.; Ravnjak, D.; Boh Podgornik, B. Antimicrobial Paper Coatings Containing Microencapsulated Cymbopogon citratus Oil. Coatings 2019, 9, 470. https://doi.org/10.3390/coatings9080470
Šumiga B, Šumiga B, Ravnjak D, Boh Podgornik B. Antimicrobial Paper Coatings Containing Microencapsulated Cymbopogon citratus Oil. Coatings. 2019; 9(8):470. https://doi.org/10.3390/coatings9080470
Chicago/Turabian StyleŠumiga, Boštjan, Barbara Šumiga, David Ravnjak, and Bojana Boh Podgornik. 2019. "Antimicrobial Paper Coatings Containing Microencapsulated Cymbopogon citratus Oil" Coatings 9, no. 8: 470. https://doi.org/10.3390/coatings9080470






